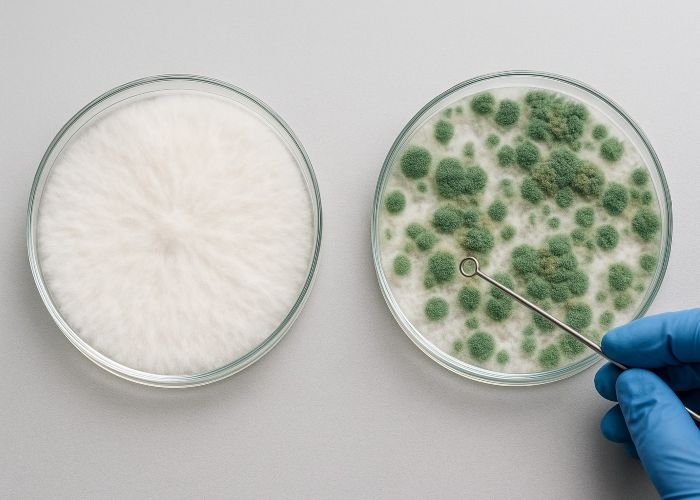

В культивации волшебных грибов существует негласное правило, которое передается из уст в уста: если вы увидели на субстрате резкую зелень — не разбирайтесь, а выбрасывайте. Без жалости и без попыток «восстановить». Потому что в девяти случаях из десяти это триходерма. И если другие плесени могут дать фору, то она действует по-другому — быстро, системно и без обратной дороги.
Триходерма — это не просто визуальный дефект и не просто контаминант, от которого можно отмахнуться. Это микроскопический захватчик, способный уничтожить весь цикл, от засева до плодоношения, еще до того, как вы поймете, что пошло не так. Она не подает громких сигналов, не пахнет, не выглядит угрожающе на первых порах. И именно в этом ее сила.
Для большинства грибоводов — вне зависимости от уровня подготовки — триходерма становится тем первым по-настоящему тяжелым столкновением с реальностью. Она ставит крест на партиях, подрывает уверенность и формирует устойчивое ощущение тревоги, где даже нормальный мицелий начинает казаться подозрительным. Это уже не просто плесень, а фактор, способный изменить весь подход к грову. И если не понять, с чем имеешь дело, — ситуация будет повторяться.
Что такое триходерма на самом деле
Триходерма — это не один конкретный гриб, а целый род (Trichoderma), объединяющий десятки видов микроскопических плесеней, обитающих в почве, на гниющей древесине, в компосте и других органических субстратах. В контексте грибоводства чаще всего сталкиваются с T. harzianum, T. aggressivum и T. viride — именно эти виды наиболее агрессивны и опасны для культивируемых грибов.
Их главное отличие от «обычной» плесени — активная паразитическая стратегия. Они не просто разлагают мертвую органику, а нападают на другие живые грибы. Это поведение называется микопаразитизмом: триходерма идентифицирует мицелий другого вида как источник пищи и целенаправленно его уничтожает.
Визуально под микроскопом это выглядит как атака. Гифы триходермы приближаются к чужому мицелию, обвивают его, плотно соприкасаются и начинают выделять ферменты — такие как хитиназа, бета-глюканаза и другие литические соединения. Эти вещества растворяют клеточную стенку гриба-жертвы, разрушая ее структуру и высвобождая содержимое, которое триходерма затем поглощает.
На практике процесс идет очень быстро. Спустя сутки после заражения можно наблюдать угнетение роста, через двое — отсутствие жизнеспособности в пораженной зоне. Мицелий становится тусклым, расплывчатым, перестает развиваться и вскоре полностью погибает. Все, что остается — бело-зеленый ковер и следы разрушения.
Маскировка на старте
Одна из главных опасностей триходермы — ее способность долго оставаться незаметной. На ранних стадиях заражения отличить ее от здорового мицелия Psilocybe cubensis может быть крайне сложно, особенно на фоне плотного белого налета, который и у здоровой грибницы бывает в избытке. Белесый пушок на поверхности субстрата — типичная картина для первой фазы роста. И именно в этой похожести кроется основная угроза: визуальная маскировка.
Ошибаются не только новички — даже опытные грибоводы иногда принимают молодую триходерму за «уверенно идущий» мицелий. На этом этапе структура колонии еще не выдает себя. Только при более пристальном наблюдении можно заметить отличия: рыхлость, неравномерность, отсутствие характерного блеска и ризоморфных нитей. Но эти признаки тонкие, и проявляются не сразу.
Когда становится действительно очевидно, что что-то не так, — уже поздно. Поверхность субстрата начинает приобретать пылеобразный вид, словно присыпанный мукой. А затем появляется зеленый цвет — признак того, что гриб вступил в фазу споруляции. Важно понимать: зеленый — это не признак зрелости, это финальная стадия победы. На этом этапе триходерма уже колонизировала субстрат, начала распространять споры и вышла за пределы локального очага.
Именно поэтому нельзя ждать «явных признаков» заражения. Критически важно следить за микроструктурой мицелия на ранней стадии, оценивать динамику роста, плотность, текстуру и оттенок. Потому что пока все выглядит «вроде нормально» — триходерма может уже работать внутри, незаметно, но неумолимо.
Откуда она берется
Триходерма не появляется из ниоткуда — она почти всегда уже рядом. Ее споры повсеместны: они легко перемещаются по воздуху, оседают на предметах, выдерживают сложные условия и могут сохранять жизнеспособность неделями, если не дольше. При этом большинство путей ее проникновения в инкубатор — банально бытовые.
Вот самые частые источники:
- Нестерильный воздух при работе с культурами. Даже один сквозняк в сторону открытой банки может занести спору внутрь. Если нет ламинарного потока или хотя бы пламени спиртовки, вы работаете в зоне риска.
- Грязные перчатки, инструменты, крышки банок. Непромытая ложка, скальпель, не проспиртованная поверхность, к которой вы случайно прикоснулись — достаточно буквально одной споры.
- Недостерилизованное зерно. Зерно, прошедшее недостаточную стерилизацию, часто становится «инкубатором в инкубаторе» — триходерма может находиться внутри зерен, не проявляя себя до начала прорастания мицелия.
- Плохо обработанный кокос. Кокосовое волокно — пористый и капиллярный материал, отлично удерживающий влагу и воздух. Это делает его идеальной средой для спор, особенно если оно не стерилизовано должным образом.
- Одежда, волосы, мобильные телефоны. Споры могут попасть внутрь на рукавах, шнурках, в волосах, на телефоне, которым вы пользовались в помещении. Даже минимальное нарушение гигиены — и риск возрастает кратно.

Иногда заражение происходит еще до инокуляции. Например, если вы используете покупной субстрат, который хранился в сыром помещении, был вскрыт и снова закрыт, или просто долго стоял в теплой среде. На первый взгляд он может быть сухим и «нормальным», но внутри уже дремлет спора триходермы.
Особенность этих спор — их живучесть. Они устойчивы к ультрафиолету, перепадам температур, сушке и даже некоторым дезинфицирующим растворам. В замкнутых пространствах, особенно в плохо вентилируемых инкубаторах, одна спора может стать началом всей колонии. Именно поэтому так важно не только соблюдать стерильность, но и относиться к каждому этапу как к потенциальной точке входа угрозы.
Почему триходерма — особый случай среди всех контаминантов
В процессе культивации грибов можно столкнуться с самыми разными загрязнителями: бактериальные колонии, дрожжи, мукоры, аспергиллы, пенициллы. Некоторые из них мешают, замедляют рост, вызывают неприятный запах или портят внешний вид субстрата. Но почти всегда с ними можно работать: изолировать, срезать, попытаться сохранить часть урожая.
С триходермой все иначе. Это не просто агрессивный сосед, а целенаправленный убийца мицелия. Вот что делает ее по-настоящему особым случаем:
- Атакует напрямую. Триходерма не просто конкурирует за питательную среду — она охотится. Ее гифы находят чужой мицелий, обвивают его, выделяют ферменты (хитиназы, глюканазы), разрушают клеточные стенки и поглощают содержимое. Это не симбиот, не соперник — это хищник.
- Обгоняет по скорости. Даже самый активный мицелий Psilocybe cubensis не способен расти с той же скоростью, что триходерма. Она разворачивается за сутки, покрывает поверхность плотным мицелием и через двое уже спорирует. Гровер просто не успевает среагировать.
- Спорирует агрессивно. Когда появляется характерный зеленый цвет — это уже не просто налет, а миллионы спор. Летучих, микроскопических, невидимых. Они оседают на инструментах, стенках бокса, одежде, руках, воздухозаборниках. И заражение переходит из локального в системное.
- Плохо поддается локальной нейтрализации. Попытки прижечь, обработать солью, кислотой или перекисью дают временный эффект, но не решают проблему. Триходерма легко восстанавливается, а если споруляция уже началась — шансов нет. Один зараженный кейк становится источником повторного заражения на недели вперед.
Режим утилизации
Когда вы обнаружили триходерму, главное — не пытаться «дорастить» и не терять время на сомнения. Зеленый налет — это уже споры. И каждое промедление увеличивает шанс, что они окажутся на соседних банках, стенках, инструментах или просто в воздухе.
Вот четкий и минимально рискованный протокол действий:
-
Герметично закрыть зараженный кейк.
Не нюхать, не рассматривать, не вскрывать. Плотно закрыть крышку или упаковать кейк в несколько слоев пленки или пакетов. Цель — изолировать споры и не дать им подняться в воздух. -
Немедленно вынести из помещения.
Только после герметизации. Лучше всего — сразу на утилизацию вне жилой зоны: в мусорный бак, на улицу, в компост (только если это не рядом с вашим гроу-пространством). -
Обработать все вокруг.
Рабочая поверхность, бокс, стол, стены — все, что могло контактировать с воздухом в момент вскрытия, нужно обработать спиртом, перекисью водорода (3–5%) или хлорсодержащим раствором (например, белизной). Особенно тщательно — углы, вентиляция, инструменты, фильтры и крышки. -
При наличии ламинарного бокса — заменить фильтры.
Даже если они выглядят «нормально». Споры оседают внутри и могут просочиться обратно при следующем запуске. Также стоит протереть корпус бокса изнутри и снаружи, включая стекло и вентиляционные решетки. -
Отложить все работы с инокуляцией минимум на 48 часов.
За это время стоит повторно провести дезинфекцию воздуха, поверхности и одежды. По возможности — проветрить помещение, использовать озонатор или УФ-лампу.
Распространенные ошибки, приводящие к вспышкам
Даже самые опытные грибоводы не застрахованы от появления триходермы — но большинство случаев заражения можно проследить до вполне конкретных ошибок. Часто это не один фатальный промах, а цепочка мелких нарушений, которые в сумме дают идеальные условия для захвата. Вот наиболее частые причины вспышек:
Слишком высокая влажность и плохая вентиляция
Влажность выше 90–95% в сочетании с застоявшимся воздухом — идеальная среда для развития триходермы. Без циркуляции воздух становится насыщен влагой и микроорганизмами, споры оседают и активируются.
Переуплотненный или переувлажненный субстрат
Субстрат должен быть воздушным, с достаточной пористостью. Плотный, влажный кейк с плохим воздухообменом быстро превращается в рассадник анаэробных зон, где плесени — в том числе триходерме — ничто не мешает развиваться.
Использование дешевого зерна без предварительного замачивания и отмывки
Некачественное зерно часто содержит споры, бактерии и остатки пестицидов. Без правильной подготовки (замачивания, промывки, стерилизации) оно становится точкой входа для контаминации.
Перенос кейков между зонами без должной изоляции
Если вы перемещаете инкубируемые блоки или кейки из одного помещения в другое, особенно через зоны с плодоношением, вентиляцией или просто бытовым трафиком — споры могут попасть на поверхность и активироваться при изменении условий.
Инокуляция без ламинарного потока или открытого пламени
Даже при «чистом» столе воздух остается неконтролируемым. Без направленного потока (ламинарного фильтра или хотя бы пламени спиртовки) любая спора в комнате может попасть в открытую банку или шприц.
Важно помнить: даже при соблюдении всех санитарных правил, абсолютной защиты от триходермы не существует. Ее споры присутствуют практически везде, и полностью исключить их невозможно. Но грамотная система работы должна снижать вероятность заражения на каждом этапе — от промывки зерна до выбора момента, когда вы открываете камеру для плодоношения. Потому что вспышка — это всегда следствие, а профилактика — единственный по-настоящему эффективный способ ее предотвратить.
Профилактика: все решается до заражения
С триходермой невозможно справиться после ее появления — и именно поэтому все важно делать до. Профилактика — не один шаг, а система, где каждое действие снижает вероятность заражения. Ниже — конкретные методы, которые действительно работают на практике.
Автоклав или скороварка
Если у вас есть доступ к полноценной стерилизации — используйте ее без компромиссов. Температура 121 °C при давлении в течение 90 минут — золотой стандарт. Особенно для зерна, кокоса, соломы и любых целлюлозных субстратов. Это первый рубеж защиты.
Маска и перчатки
Не для красоты и не по инерции, а как элемент санитарного барьера. Перчатки обрабатываются спиртом или хлоргексидином перед каждым этапом, маска защищает субстрат от вашего дыхания. Даже один вдох над открытой банкой — потенциальный путь для споры.
Ламинарный бокс или открытое пламя
Все действия с открытием банок, шприцов, игл — только в стерильной зоне. Если нет бокса, используйте спиртовку или газовую горелку, чтобы создать восходящий поток, отсекающий споры из воздуха. Без этого вы работаете вслепую.

Перекись водорода (3%) + пульверизатор
Перекись — универсальный дезинфектант, и в формате мелкодисперсного распыления работает эффективно. Обрабатывайте поверхности, крышки, инструменты, перчатки. Не трите — распыляйте. Повторяйте процедуру регулярно.
Контроль температуры и влажности
Триходерма плохо развивается при относительной влажности 55–60% и температуре ниже 23 °C. Во время инкубации следите, чтобы не было перегрева и конденсата — избыточная влага ускоряет развитие плесени.
Дополнительные меры для бытовых условий:
- Перед началом работы переоденьтесь в чистую одежду
- Телефон уберите или тщательно продезинфицируйте
- Не проводите операции рядом с подоконниками, вентиляцией, шторами
- Не перемещайте банки через «грязные» зоны
- Не заходите в инкубационную зону после прогулки без смены одежды
Профилактика работает только тогда, когда она непрерывна. Один пропущенный этап, одна «забытая перчатка» или «быстро открою банку» могут перечеркнуть все. Триходерма не прощает небрежности — но и не проникает туда, где все под контролем.
Немного цифр: биология триходермы
Чтобы понять, почему триходерма так быстро и беспощадно захватывает субстрат, достаточно взглянуть на ее базовые биологические параметры. Это не просто гриб — это идеально отлаженный механизм вытеснения конкурентов.
Оптимальная температура роста: 25–30 °C
При такой температуре триходерма демонстрирует максимальную скорость развития и ферментативную активность. Совпадение с условиями инкубации Psilocybe cubensis делает ее особенно опасной.
Время до начала споруляции: 24–48 часов
Это значит, что между моментом заражения и началом массового распространения спор может пройти всего один день. Промедление в реакции — почти гарантированное вторичное заражение.
Диапазон устойчивости по pH: от 4 до 8
Такая толерантность позволяет триходерме развиваться практически в любом субстрате, даже если среда слабо подкислена или ощелочена. Она легко адаптируется.
Скорость роста: до 3–5 мм в час
В условиях высокой влажности и достаточной вентиляции триходерма может визуально увеличиваться буквально на глазах. Ни один культивируемый гриб не развивается с такой скоростью.
Антагонистический потенциал: до 15 известных ферментов подавления
Среди них — хитиназы, β-глюканазы, протеазы, целлюлазы и другие соединения, разрушающие структуру чужого мицелия. Это позволяет ей не просто конкурировать, а химически уничтожать соперников.
По сути, триходерма — это фабрика биохимического подавления. Она не просто растет — она действует. У нее нет пассивной фазы, нет паузы, нет «ожидания условий». Как только она получает доступ к среде — она начинает работать: распознавать, атаковать, подавлять. Ее стратегия — не делить субстрат, а завоевать его полностью.
Фермерский парадокс
Пожалуй, одна из самых ироничных деталей, связанных с триходермой, — ее репутация в агросекторе. В сельском хозяйстве она считается полезным микроорганизмом: природным биофунгицидом, способным подавлять фузариоз, питиум, ризоктонию и другие почвенные патогены. Trichoderma harzianum входит в состав десятков коммерческих препаратов, которые продаются в садовых магазинах под видом пробиотиков для почвы и стимуляторов корневого роста. Ее добавляют в рассадные смеси, компост, мульчу — и получают отличные результаты.
Но то, что хорошо для растения, — катастрофично для гриба. Грибоводу триходерма в субстрате — все равно что волк в овчарне. Особенно если речь идет о Psilocybe cubensis или других чувствительных к микопаразитам видах. Там, где растение получает защиту от патогенов, мицелий гриба сталкивается с хищником, который воспринимает его не как соседа, а как еду.
Именно поэтому советы вроде «добавьте триходерму для улучшения микрофлоры» или «обогатите компост биоконтролем» в контексте культивации волшебных грибов не просто бесполезны — они опасны. То, что работает в теплице с томатами или на грядке с салатом, в инкубаторе с Psilocybe превращается в сценарий быстрого заражения.
Этот парадокс еще раз подчеркивает, насколько важно различать контексты. Один и тот же организм может быть союзником или врагом — все зависит от того, в чьей системе он оказался. В мире грибоводов триходерма — не биофунгицид. Это самый опасный из всех возможных захватчиков.
Выводы: что важно запомнить
Триходерма — это не досадное недоразумение и не случайная плесень, которую можно «прижечь и забыть». Это организованный, быстрый и высокоадаптивный контаминант, способный уничтожить не только одну банку, но и поставить под угрозу весь цикл культивации. Она не оставляет времени на размышления и не дает второго шанса.
Главный принцип в работе с триходермой — не лечить, а не допустить. Профилактика, стерильность, дисциплина, санитарный контроль — это не рекомендации, а основа микологической безопасности. Заражение, как правило, означает фатальное развитие событий.
Ни один кейс, даже самый перспективный, не стоит риска вторичного заражения всего помещения. Поэтому важное умение грибовода — не только выращивать, но и вовремя выбрасывать. Без сожаления, без попыток «спасти», без откладывания решения.
Чем раньше вы научитесь распознавать триходерму, тем меньше она будет вас учить на практике. Потому что с ней нет компромиссов — только четкие действия, скорость и безусловный контроль среды.
Источники:
- Fungi Academy. Mushroom contamination: How to spot and what to do.
- Grow Magik. Trichoderma in monotub mushroom growing.
- Alchimia Grow Shop. Contamination in magic mushroom cakes, what to do and how to prevent it?





Будьте первым!